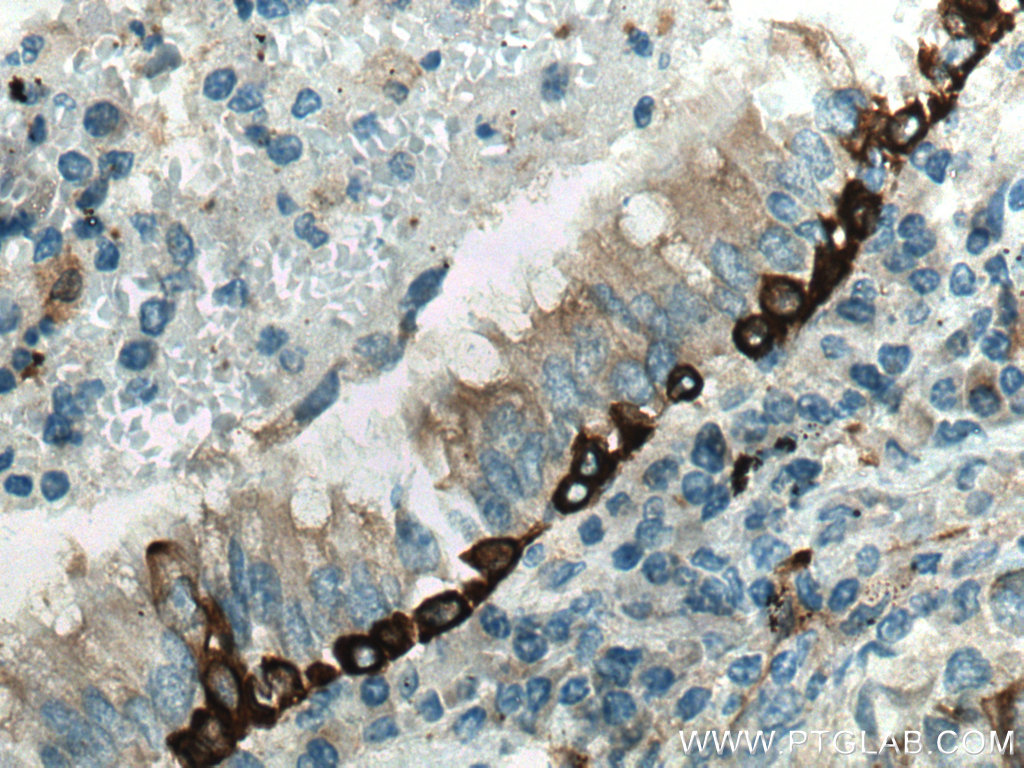

验证数据展示
经过测试的应用
| Positive WB detected in | A431 cells, mouse skin tissues, rat skin tissues |
| Positive IHC detected in | human tonsillitis tissue, human brown disease, human lung cancer tissue Note: suggested antigen retrieval with TE buffer pH 9.0; (*) Alternatively, antigen retrieval may be performed with citrate buffer pH 6.0 |
| Positive IF-P detected in | human tonsillitis tissue |
| Positive IF/ICC detected in | A431 cells |
推荐稀释比
| 应用 | 推荐稀释比 |
|---|---|
| Western Blot (WB) | WB : 1:1000-1:6000 |
| Immunohistochemistry (IHC) | IHC : 1:1000-1:4000 |
| Immunofluorescence (IF)-P | IF-P : 1:50-1:500 |
| Immunofluorescence (IF)/ICC | IF/ICC : 1:400-1:1600 |
| It is recommended that this reagent should be titrated in each testing system to obtain optimal results. | |
| Sample-dependent, Check data in validation data gallery. | |
发表文章中的应用
| WB | See 2 publications below |
| IF | See 7 publications below |
产品信息
28506-1-AP targets Cytokeratin 5 in WB, IHC, IF/ICC, IF-P, ELISA applications and shows reactivity with human, mouse, rat samples.
| 经测试应用 | WB, IHC, IF/ICC, IF-P, ELISA Application Description |
| 文献引用应用 | WB, IF |
| 经测试反应性 | human, mouse, rat |
| 文献引用反应性 | human, mouse |
| 免疫原 |
CatNo: Ag25436 Product name: Recombinant human KRT5 protein Source: e coli.-derived, PGEX-4T Tag: GST Domain: 6-60 aa of BC024292 Sequence: SVSFRSGGSRSFSTASAITPSVSRTSFTSVSRSGGGGGGGFGRVSLAGACGVGGY 种属同源性预测 |
| 宿主/亚型 | Rabbit / IgG |
| 抗体类别 | Polyclonal |
| 产品类型 | Antibody |
| 全称 | keratin 5 |
| 别名 | CK 5, CK-5, keratin 5, KRT5, 58 kDa cytokeratin |
| 计算分子量 | 590 aa, 62 kDa |
| 观测分子量 | 62 kDa |
| GenBank蛋白编号 | BC024292 |
| 基因名称 | Cytokeratin 5 |
| Gene ID (NCBI) | 3852 |
| RRID | AB_2881159 |
| 偶联类型 | Unconjugated |
| 形式 | Liquid |
| 纯化方式 | Antigen affinity purification |
| UNIPROT ID | P13647 |
| 储存缓冲液 | PBS with 0.02% sodium azide and 50% glycerol, pH 7.3. |
| 储存条件 | Store at -20°C. Stable for one year after shipment. Aliquoting is unnecessary for -20oC storage. |
背景介绍
Cytokeratin 5 (CK5) is a type II intermediate filament protein predominantly expressed in basal epithelial cells of various tissues, including the skin, breast, salivary glands, urinary tract, and upper aerodigestive tract. It is commonly found in specialized cell types such as squamous cells, basal cells, and myoepithelial cells. CK5 forms heterodimers with cytokeratin 14 and plays a crucial role in providing structural support to epithelial cells
实验方案
| Product Specific Protocols | |
|---|---|
| IF protocol for Cytokeratin 5 antibody 28506-1-AP | Download protocol |
| IHC protocol for Cytokeratin 5 antibody 28506-1-AP | Download protocol |
| WB protocol for Cytokeratin 5 antibody 28506-1-AP | Download protocol |
| Standard Protocols | |
|---|---|
| Click here to view our Standard Protocols |
发表文章
| Species | Application | Title |
|---|---|---|
Stem Cell Res Ther Mesenchymal stromal cells promote the formation of lung cancer organoids via Kindlin-2 | ||
J Invest Dermatol Circulating Exosomal miR-493-3p Affects Melanocyte Survival and Function by Regulating Epidermal Dopamine Concentration in Segmental Vitiligo. | ||
FASEB J Sperm immotility is associated with epididymis metabolism disorder in mice under obstructive azoospermia | ||
Hum Gene Ther Lentiviral Gene Delivery Rescues Ciliary Defects in Patient-Derived Airway Organoids from Primary Ciliary Dyskinesia | ||
J Clin Lab Anal Hsa_circRNA_0017620 regulated cell progression of non-small-cell lung cancer via miR-520a-5p/KRT5 axis. | ||
Nat Commun Nanostructured organic sheets sequestering small extracellular vesicles and reactive species to protect against radiation-induced mucositis |